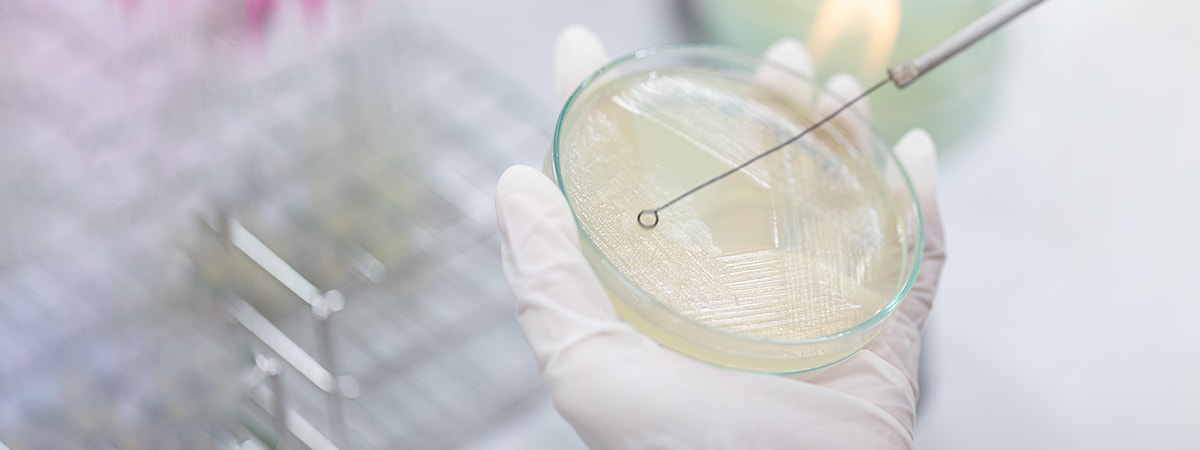
Yeast Growth Monitoring with TURBIDI.T™ in Bioreactor - Blog Post Image

Rheolution's Resources in Life Sciences
Documents to help you start your Soft Matter Analytics™ Journey
APPLICATION NOTES
Case studies done by Rheolution’s application specialists
APPLICATION NOTES
Case studies done by Rheolution’s application specialists
The mechanical characterization of biological soft membranes such as skin, pericardium, or hydrogel-based samples is challenging and often results in sample damage. The Membrane Sample Holder of the ElastoSens™ Bio has been designed for facilitating the loading and the handling of membrane samples allowing proper mechanical testing. In this study, the elasticity of bovine pericardium membranes were precisely measured using the ElastoSens™ Bio...
Enzymes are commonly used in the field of regenerative medicine to degrade native tissues for the extraction of cells and other components, or as a part of physiological-like fluids to mimic in vivo conditions for biomaterials in development. The performance of enzymes can be measured in terms of weight loss or mechanical properties. The viscoelastic properties of kidney tissue during incubation with collagenase was precisely measured using the ElastoSens™ Bio...
Growing demands for quicker cell quantification methods push beyond traditional cell counting chambers, prompting innovative solutions that facilitate accurate counting while diminishing time. Turbidity, reflecting solution cloudiness in the presence of light scatterers, emerges as an effective means to accelerate cell quantification.
In the realm of bioengineering and biotechnology, cells serve as catalysts for the production of diverse valuable products, such as biofuels, pharmaceuticals, antibodies, industrial enzymes, and bio-based chemicals [1]. Within this context, yeast, a widely utilized microorganism, plays a pivotal role. Monitoring yeast growth is of utmost importance to ensure optimal conditions and productivity in biotechnological processes [2]. Traditionally, spectrophotometric analysis has been used to assess the optical density at 600 nm (OD600nm) by measuring the absorption of light by the yeast ...
The sedimentation kinetics of suspended particles provides crucial information for optimizing manufacturing and infrastructure across industries, while also contributing to the design of drugs and cell therapies. Turbidimetry is a quick and nondestructive method to precisely determine the sedimentation kinetics of suspended particles.
The determination of particle size is important in many fields, such as life sciences (nanomedicine, drug delivery, tissue engineering, bioanalysis), chemical, environmental sciences and industries. Turbidimetry is a quick and nondestructive method to estimate particle size following an easy-to-follow procedure.
TECHNICAL NOTES
These articles provide further technical details and specifications about the topic treated in these publications
TECHNICAL NOTES
These articles provide further technical details and specifications about the topic treated in these publications
ELASTOSENS™ BIO HOW TO SERIES
ELASTOSENS™ BIO HOW TO SERIES
01. Installation of the ElastoSens™ Bio
02. Daily Vibration Calibration for ElastoSens™ Bio
03. Configure a Test on the ElastoSens™ Bio
04. Build Test Sequences with ElastoSens™ Bio
05. Data Visualisation on the ElastoSens™ Bio App
06. Export ElastoSens™ Bio’s data to Excel
07. Retest a sample using the ElastoSens™ Bio
08. Create custom fields on the ElastoSens™ Bio
09. Create custom buttons on the ElastoSens™ Bio
10. How to clean the ElastoSens™ Bio
11 .Calibrate the temperature of the ElastoSens™ Bio
12. Calibrate the height of the ElastoSens™ Bio
13. How to use the µ-volume sample holder for ElastoSens™ Bio?
14. How to use the Membrane Sample Holder for ElastoSens™ Bio?
RHEOLUTION ARTICLES
Original articles prepared by our application specialists commenting on topics of interest to our community
RHEOLUTION ARTICLES
Original articles prepared by our application specialists commenting on topics of interest to our community
ARTICLES OF THE MONTH
Each month, a published scientific article that covers a theme of interest to our community is summarized and commented by our application specialists
ARTICLES OF THE MONTH
Each month, a published scientific article that covers a theme of interest to our community is summarized and commented by our application specialists
SCIENTIFIC PUBLICATIONS
Published scientific articles using Rheolution’s instruments
SCIENTIFIC PUBLICATIONS
Published scientific articles using Rheolution’s instruments
EXPERT CORNER
EXPERT CORNER